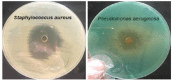

Antibacterial and Anticancer Activities of Fenugreek Seed Extract
- PMID: 31870120
- PMCID: PMC7173369
- DOI: 10.31557/APJCP.2019.20.12.3771
Antibacterial and Anticancer Activities of Fenugreek Seed Extract
Abstract
This work is about the utilization of fenugreek seed as an antibacterial and anticancer agents. The antibacterial activity of fenugreek seed extract on six pathological bacteria strains were specified through conventional biochemical tests using the Vitek2 automated system and diffusion agar method. The anticancer activities of fenugreek seed extract, on MCF-7 breast cancer cells, liver cancer HCAM cells and the non-cancerous Vero cell lines, were investigated using colorimetric MTT assay. Results showed that the highest activity of the extract of the seed was found on Staphylococcus aureus and Pseudomonas aeruginosa (22 mm and 17 mm diameter of inhibition zones respectively). The seed extract showed proliferative inhibition on MCF-7 cell line at a concentration of 400 µg/ml and 72 h of the incubation period. This was accompanied by insignificant apoptosis or necrosis. The seed extract showed no anticancer effect on liver and Vero cell lines. This work emphasizes that fenugreek seed extract is a potential source of antibacterial and anticancer agents.<br />.
Keywords: Antibacterial effect; Fenugreek seed; Pathogenic bacteria; breast cancer.
Figures

References
-
- Alwan AM, Jassim IM, Jasim GM. Study of antibacterial activities of seed extract of fenugreek (Trigonella foenum-graecum) Diyala J Med. 2017;13:1.
-
- Alwan N. Iraqi initiative of a regional comparative breast cancer research project in the Middle East. J Cancer Biol Res. 2014;2:1016–20.
-
- Alwan NA. Breast cancer: Demographic characteristics and clinico-pathological presentation of patients in Iraq. East Mediterr Health J. 2010;16:1159–64. - PubMed
-
- Amenu D. Antimicrobial activity of medicinal plant extract and their synergistic effect on some selected pathogens. Amer J Ethno Med. 2014;1:18–29.
-
- Amin A, Alkaabi A, Al-Falasi S, Daoud SA. Chemopreventive activities of Trigonella foenum graecum (Fenugreek) against breast cancer. Cell Biol Int. 2005;29:687–94. - PubMed
MeSH terms
Substances
LinkOut - more resources
Full Text Sources
Medical